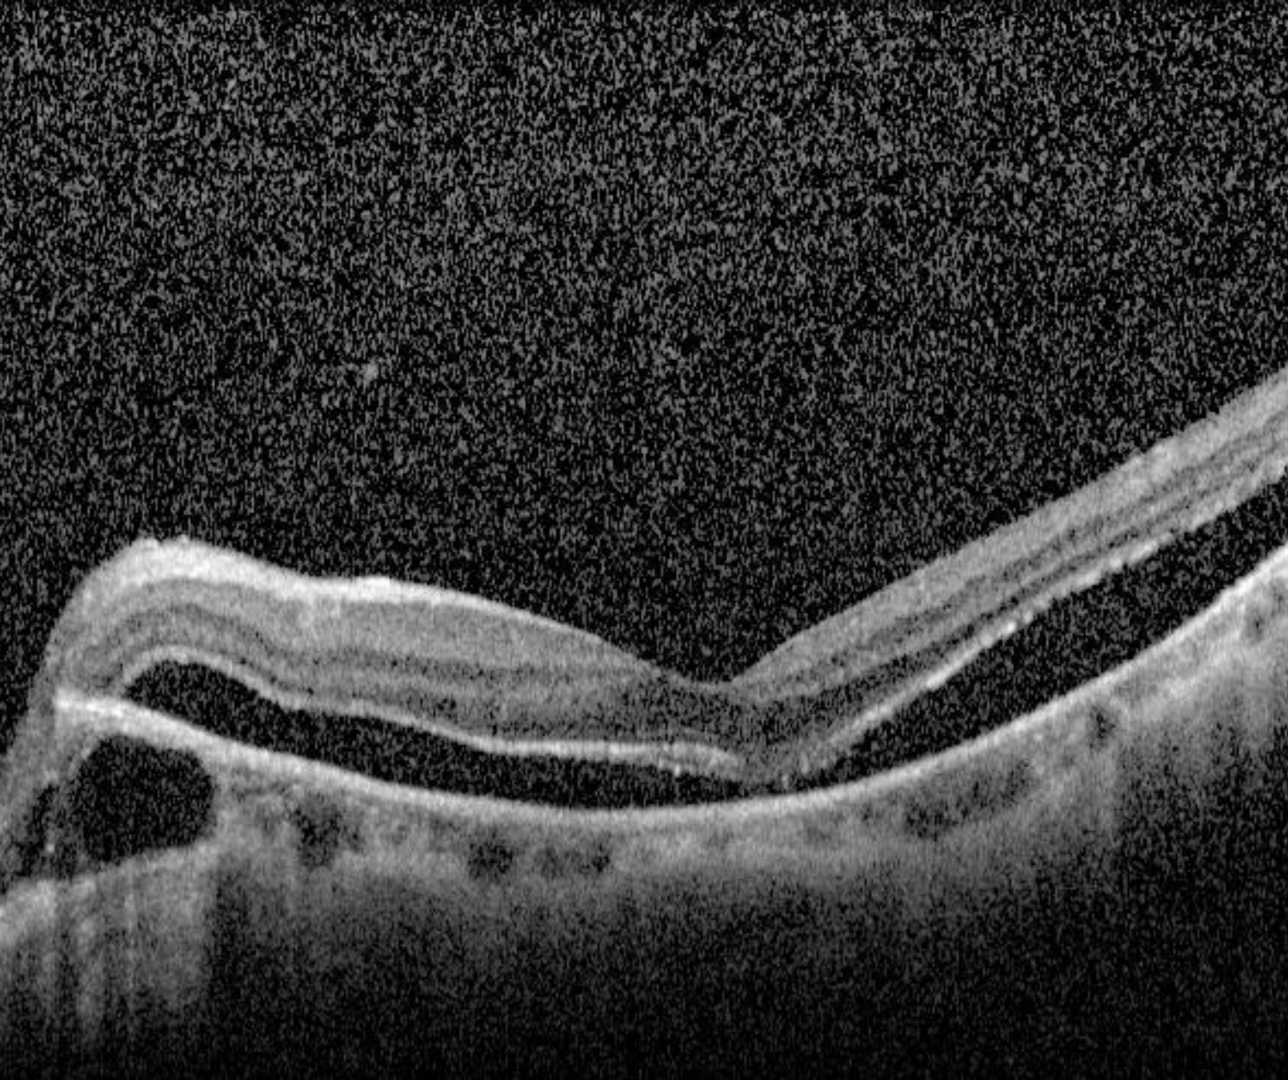

- Overview
- Case Examples
- Differential Diagnosis (Foveoschisis)
- Differential diagnosis (Myopic Macular Hole)
- Differential Diagnosis (Foveal Detachment)
- References
Overview
Myopic tractional maculopathy (MTM) is a term used to described various findings associated with traction in highly myopic eyes.
MTM is thought to occur due to the tractional forces exerted by the vitreomacular interface or epiretinal membrane, ILM rigidity and progressive extension of the posterior staphyloma.
Tractional changes associated with myopia may include:
1. Foveoschisis / retinoschisis
2. Paravascular cysts and schisis
3. Vascular microfolds
4. Foveal detachment
5. Full thickness macula hole (myopic macula hole)
All are associated with increased axial length, chorioretinal atrophy and vitreoretinal interface disorders.
Myopic foveoschisis presents as a separation of the retinal layers (most commonly the outer retinal layers). It may be slowly progressive, leading to foveal detachment or a macular hole. The foveoschisis can occur at the inner retinal layers, outer retinal layers and involve both (compound schisis). The patient may initially be asymptomatic but vision loss and metamorphopsia can occur as the condition progresses.
The term foveal detachment refers to a separation of the neurosensory retina from the RPE at the fovea.
A full thickness (myopic) macula hole occurs secondary to tractional forces in the presence of vitreomacular adhesion. If an epiretinal membrane is present and exerting a tractional force, the risk of hole formation is increased. This presentation is associated with severe vision loss and the prognosis is poor, potentially leading to retinal detachment if left untreated.
Case Examples
-
Case 1: Foveoschisis
A 64 year old Asian male. Refraction is-10.25 / -1.25 x 90 and visual acuity 6/7.5- (20/25-).
-
Case 2: Foveal detachment
A 59 year old Asian male with refraction -9.75 / -2.00 x 70 and visual acuity 6/12 (20/40).
-
Case 3: Full thickness (myopic) macula hole
A 61 year old Asian female with refraction -7.50 / -6.50 x 180 and visual acuity 6/15- (20/50-).
Differential Diagnosis (Foveoschisis)
Differential diagnosis (Myopic Macular Hole)
Differential Diagnosis (Foveal Detachment)
References
Ng, D., Cheung, C., Luk, F. et al. (2016) Advances of optical coherence tomography in myopia and pathologic myopia. Eye 30, 901–916
Yasushi, I. (2017) Overview of the complications of high myopia, Retina: Volume 37 - Issue 12 - p 2347-2351


